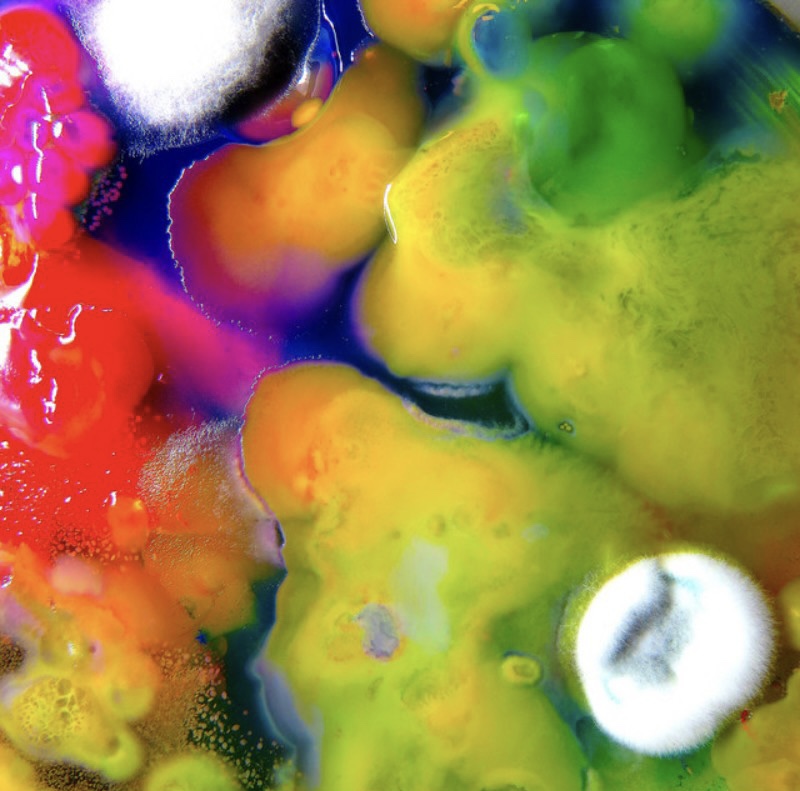

Written by: Briyanna Wilson
Over 100 albums, and over 2,000 tracks worth of music sorted by genre. Here are all of our favorite projects of 2022. List includes Mixtapes, EP’s, and Albums. Please note: all projects categorized by how they were submitted to DSP’s.
- HIP-HOP/RAP (no particular order)
SICK!: Earl Sweatshirt

broken communication from the outer rim Blakchyl HYAH!

Better Than Money: V Don

FACE: Babyface Ray

Few Good Things: Saba

Continuance: Curren$y

Digital Roses Don’t Die: Big K.R.I.T.

God Don’t Make Mistakes: Conway the Machine

Fast Trax 3: 454

TheHouse Presents: The Set TheHouse

Driplomatic Immunity: Smoke DZA

2 P’z In A Pod: Jay Worthy, Larry June, LNDN DRGS

Siddhi World: ICYTWAT

Key2TheLock: Ken Casio

Jazz Codes: Moor Mother

Talk To Him Nicely: Coach Tev

Aethiopes: billy woods

RAMONA PARK BROKE MY HEART: Vince Staples

It’s Almost Dry: Pusha T

Simple: IDK

Mr. Morale & The Big Steppers: Kendrick Lamar

Neptune: MC Righteous

Diary of a Loner: Reo Cragun

Lost Souls: Vory

The Highest Flyest Fly on the Wall: Pat Ron

In My Head: YGTUT

MORE BLACK SUPERHEROES: WESTSIDE BOOGIE

Vinyl Days: Logic

The Garden Project: Jahn Dough

The Blue Hour: Rexx Life Raj

Las Ruinas: Rico Nasty

CRUNKSTAR: Duke Deuce

5th Wheel Fairytale: Deezie Brown

Intro, Outros & Interludes: Domo Genesis

Traumazine: Megan Thee Stallion

Cheat Codes: Danger Mouse, Black Thought

To Whom Much Is Given: Cush With a C

The Elephant Man’s Bones: Roc Marciano & The Alchemist

The Forever Story: JID

Black Vladimir: Mayhem Lauren & Daringer

2 Slizzy 2 Sexy: Cash Cobain, Chow Lee

STUNNA: P-Lo

Long Live DJ Shay: Black Soprano Family

I Never Felt Nun: EST Gee

KISS THE RING: Rome Streetz

Laughing so Hard, it Hurts: MAVI

10: Westside Gunn

Her Loss: Drake, 21 Savage

S.L., Vol. 1: Soupmakesitbetter

Pink Heartz: SoFaygo

Boogie Man Wick: Shawny Binladen

Tempus Act II: Mirrors Issa Gold

Lebra Jolie: Lebra Jolie

Non-Perishable: tobi lou

HERBERT: Ab-Soul

Beware of the Monkey: MIKE

Pote Day 2: Pote Baby

God’s Timing: Soupmakesitbetter, Ifé Neuro

Mr. October: Coach Tev

A Tower and Thereafter: Chucky Blk

No Rest For The Wicked: Ransom

Green Alchemy: Free Hamze

Luv 4 Rent: Smino

The Alchemist Sandwich: The Alchemist

IMMORTAL: SwuM, GRIMM Doza

DS4EVER: Gunna

- R&B/Soul (no particular order)
Synergy: TYuS

Dawn FM: The Weeknd

WHAT I NEVER TOLD YOU- Grace Sorensen

Don’t Say I Didn’t Warn You- Nija

Starfruit: Moonchild

CONTEXT: Shanzyan

Don’t Wait Up: DRAMA

JúJú & The Flowerbug: Sunni Colón

Tunnel Vision: Reuben James

HYPNOS: Ravyn Lenae

Towards The Sun: AUGUST 08

H3arsummuzik: M3cca, Mufasa Enzor

As Time Goes By: Kadeem Tyrell

WASTELAND: Brent Faiyaz

The Lead: FLO

Gemini Rights: Steve Lacy

b l u r r: Xavier Omär

BEFORE WE GO (DEEPER): India Shawn

Hummingbird: bLAck pARty

Goûter: Lou Val

Kinda Happy, Kinda Sad: Zilo

Natural Brown Prom Queen: Sudan Archives

Yam Grier: Zyah Belle

Wanderlust: Durand Bernarr

Luv N Chaos: Flwr Chyld

Morfo: Charlotte Dos Santos

LET IT RAIN EP: Leven Kali

SATIN: DESTIN CONRAD

Y5: Yuna

Euphonyus: Phony Ppl

SOS: SZA

U > Everything Else: Jonny Jukebox

Remember Your North Star: Yaya Bey

Marigold: Alex Isley

Forest in the City: UMI

flora + fana: Fana Hues

BEFORE IT’S TOO LATE: Siergio

Getaway- EP: Orion Sun

- Alternative/Indie (no particular order)
And In The Darkness, Hearts Aglow: Weyes Blood

Squeeze: SASAMI

Alpha Games: Bloc Party

You Can’t Kill Me: 070 Shake

SHADES OF BLUE: P$O Kwama

Sometimes, Forever: Soccer Mommy

Dragon New Warm Mountain I Believe In You: Big Thief

I’m In Love: Freak Slug

Physical Thrills: Silversun Pickups

Flood: Stella Donnelly

DECIDE: Djo

Four Songs- EP: Blood Orange

Hold The Girl: Rina Sawayama

Pocket Fantasy: Mamalarky

The Car: Arctic Monkeys

Myself in the Way: Turnover

Alpha Zulu: Phoenix

I’ve Run From Love- EP: Graham Malice & Yellow Jones

Famously Alive: Guerilla Toss
A fool’s paradise (EP): Moni’ye

ONE WAY TICKET: Prixmo

Ants From Up There: Black Country, New Road

Diaspora Problems: Soul Glo

Being Funny in a Foreign Language: The 1975

Ugly Season: Perfume Genius

11: SAULT

- Rock/Metal (no particular order)
Epigone: Wilderun

IMPERA: Ghost

The New Dark Ages: Gwar

<COPINGMECHANISM>: WILLOW

Divisive: Disturbed

- Pop (no particular order)
Harry’s House: Harry Styles

Catch Me If You Can: Adekunle Gold

Thorns EP: Mallory Merk

Sahar: Tamino

Dirt Femme: Tove Lo

RENAISSANCE: Beyoncé

Ivory: Omar Apollo

- Dance/Electronic (no particular order)
Yesterday Is Heavy: Lil Silva

Nymph: Shygirl

CAPRISONGS: FKA Twigs

Whats Real: DBN Gogo

vKiSS: Dazegxd

Cooperville: Pabi Cooper

MATA: M.I.A.

VF VOL II: Sam Gellaitry

Black Girl Magic: Honey Dijon

- Latino Pop/Latin/Urbano Latino (no particular order)
MOTOMAMI: ROSALÍA

Fórmula, Vol. 3: Romeo Santos

FELIZ CUMPLEAÑOS FERXXO TE PIRATEAMOS EL ÁLBUM: Feid

Un Verano Sin Ti: Bad Bunny

- Worldwide/Amapiano/African
More Love, Less Ego: Wizkid

Chapter X: Mavins

Playboy: Fireboy DML

Mr. Money With The Vibe: Asake

KOA II Part 1: Kabza De Small

- Reggae
Gifted: Koffee

- Jazz
NOT TiGHT: DOMi & JD BECK


Leave a comment